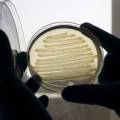

Τι νομίζετε ότι περιέχει περισσότερες πληροφορίες, το DNA που συνθέτει τον οργανισμό μας ή όλα τα ψηφιακά δεδομένα που υπάρχουν στη Γη; Το ερώτημα δεν τέθηκε από εμάς αλλά από τον Ντέρεκ Μίλερ, φυσικό ο οποίος έχει γίνει διάσημος ανά… Read More ›
ΒΙΟΛΟΓΙΑ
Χίλιες φορές πιο γρήγορα η εξαφάνιση των ειδών
Ο πλανήτης μας βρίσκεται στα πρόθυρα μιας νέας μαζικής εξαφάνισης των ειδών του -της έκτης στα 4,5 δισεκατομμύρια χρόνια της ύπαρξής του- καθώς τα ζώα και τα φυτά εξαφανίζονται με ρυθμό τουλάχιστον 1.000 φορές πιο γρήγορο σε σχέση με την… Read More ›
Δημιούργησαν εξωτικό DNA με 3 ζεύγη συζυγών βάσεων
Δύο νέα γράμματα στο «αλφάβητο» της ζωής Ένα ακόμη σημαντικό -και, για κάποιους, επίμαχο- βήμα πραγματοποιήθηκε στο πεδίο της συνθετικής βιολογίας, καθώς το «αλφάβητο» της ζωής μεγάλωσε με τεχνητό τρόπο και απέκτησε πλέον έξι γράμματα, αντί για τα τέσσερα που… Read More ›
Η ανακάλυψη της διπλής έλικας του DNA …
… από τους J.D. Watson και F.H.C. Crick, δημοσιεύθηκε σαν σήμερα O James D. Watson αναφέρει χαρακτηριστικά στο βιβλίο του «Η διπλή έλικα»: «….Ο Francis και εγώ στεκόμασταν από πάνω της (την αδερφή του Watson) ενώ εκείνη δακτυλογραφούσε το άρθρο των εννιακοσίων λέξεων… Read More ›
O κοροναϊός MERS
O κοροναϊός MERS (Middle East respiratory syndrome coronavirus – Αναπνευστικό σύνδρομο Μέσης Ανατολής) ανήκει στους κοροναϊούς (CoV) – μία οικογένεια στην οποία ανήκουν οι ιοί του απλού κρυολογήματος αλλά και ο SARS (Severe acute respiratory syndrome – Σοβαρό οξύ αναπνευστικό σύνδρομο), ο οποίος… Read More ›
Οι πρωτεΐνες της ζωής
Επιτρέπουν στο ωάριο και στο σπερματοζωάριο να «συναντηθούν» Βρετανοί επιστήμονες ανακάλυψαν μια πρωτεΐνη που παίζει ρόλο- κλειδί στη γονιμοποίηση, καθώς επιτρέπει στο ωάριο και στο σπερματοζωάριο να «συναντηθούν» κάνοντας έτσι το πρώτο ουσιώδες βήμα για τη σύλληψη και την ανάπτυξη… Read More ›
Το πρώτο τεχνητό χρωμόσωμα ευκαρυωτικού κυττάρου
Ένα βήμα – ορόσημο στο πεδίο της βιολογίας έκαναν επιστήμονες από τις ΗΠΑ, τη Γαλλία, τη Βρετανία και την Ινδία, που κατάφεραν για πρώτη φορά να δημιουργήσουν εξ’ αρχής ένα πλήρως συνθετικό και λειτουργικό χρωμόσωμα, μία εξέλιξη που ανοίγει το… Read More ›
Βρύα στην Ανταρκτική περίμεναν 1500 χρόνια να αναστηθούν
Βρύα θαμμένα επί 1.500 χρόνια στους πάγους της Ανταρκτικής ξαναζωντάνεψαν στο εργαστήριο βρετανών επιστημόνων. Το επίτευγμα, το οποίο αποδεικνύει για πρώτη φορά ότι αρχαία βλάστηση μπορεί να επιζήσει για τόσο μεγάλο χρονικό διάστημα και να επανέλθει στη ζωή αν έχει… Read More ›
Ένα βακτήριο που «τρέφεται» με ηλεκτρόνια
Από όλες τις δίαιτες που έχουν εμφανιστεί ως σήμερα στη Γη, αυτή πρέπει να είναι η πιο περίεργη: ένα βακτήριο που φημίζεται για την ικανότητά του να τρέφεται με ό,τι βρει διαθέσιμο αποδεικνύεται τώρα ότι μπορεί να ζει με φως… Read More ›
Η πρώτη ακτινογραφία ζωντανού κυττάρου
Η μέθοδος επιτρέπει για πρώτη φορά τη μελέτη των κυττάρων με λεπτομέρεια, χωρίς να προκαλεί αλλαγές στη δομή τους Για πρώτη φορά επιστήμονες κατάφεραν να δουν με τη μεγαλύτερη δυνατή λεπτομέρεια το εσωτερικό ζώντων κυττάρων σε μοριακό επίπεδο. Ομάδα γερμανών… Read More ›
Ένας ιός ηλικίας 30 χιλιάδων ετών
Ο ιός βρέθηκε παγωμένος στο υπεδάφος της Σιβηρίας και οι επιστήμονες τον «ξαναζωντάνεψαν». Σε σχέση με τα συνήθη μεγέθη των ιών θεωρείται γιγαντιαίος – έχει το μεγαλύτερο μέγεθος από όλους τους γνωστούς μέχρι σήμερα ιούς, με μήκος 1,5 εκατομμυριοστά του… Read More ›
Το μυστηριώδες χρωμόσωμα Χ
Oμολογουμένως ο όρος «χρωμόσωμα Χ» αποπνέει έναν αέρα μυστηρίου. Πρόκειται για ένα όνομα που εμπνεύστηκε το 1891 ο βιολόγος Χέρμαν Χένκινγκ, ο οποίος αναζητούσε να ανακαλύψει τη φύση των χρωμοσωμάτων στα κύτταρα που έβαζε στο μικροσκόπιό του. Οπως διαπίστωσε, όλα… Read More ›
Γιατί δεν βλέπουμε το υπεριώδες φως ;
Γάτες και σκύλοι «βλέπουν στο υπεριώδες» Τα ανθρώπινα μάτια μάλλον δεν θα έβλεπαν ένα άσπρο κουνελάκι που τρέχει στο χιόνι, όμως οι σκύλοι και ειδικά οι γάτες πιθανότατα θα μπορούσαν: ερευνητές που εξέτασαν τα μάτια μιας πληθώρας θηλαστικών διαπιστώνουν ότι… Read More ›
Βίντεο: νανοκινητήρες μέσα σε ζωντανά κύτταρα
Επιστήμονες στης ΗΠΑ κατάφεραν να εισάγουν για πρώτη φορά μικροσκοπικούς συνθετικούς νανοκινητήρες μέσα σε ζωντανά ανθρώπινα κύτταρα, τους οποίους μάλιστα κατάφεραν να τηλεκατευθύνουν μέσω υπερηχητικών κυμάτων και μαγνητικών δυνάμεων.Οι νανοκινητήρες, έχουν σχήμα πυραύλου και στην ουσία είναι μεταλλικά σωματίδια, που… Read More ›
Eκτύπωση ζωντανών κυττάρων
Η εκτύπωση ζωντανών κυττάρων σχεδόν οποιουδήποτε σχήματος είναι πλέον εφικτή χάρη σε μια νέα τεχνολογία, όπως ανακοίνωσαν Αμερικανοί ερευνητές. Η μέθοδος, με την ονομασία BlocC (Block Cell Printing), θα μπορούσε να αξιοποιηθεί για τη δημιουργία εγκεφαλικών κυττάρων κατάλληλων για εργαστηριακά… Read More ›
Νέα επαναστατική τεχνική «cut-and-paste» του DNA
Μια μέθοδος απλούστερης και ταχύτερης «χειραγώγησης» του DNA κατά βούληση ανοίγει το δρόμο σε μια νέα εποχή γενετικής ιατρικής. Η τεχνική -ένα είδος «cut-and-paste» των γονιδίων- επιτυγχάνει την ακριβέστερη τροποποίηση (κατευθυνόμενη μετάλλαξη) του γενετικού υλικού ενός ζωντανού οργανισμού. Το επίτευγμα… Read More ›
Mimosa Pudica: ένα φυτό με «νοημοσύνη»
Το «έξυπνο» φυτό που μαθαίνει και θυμάται Η μιμόζα-μη μου άπτου μαθαίνει ότι οι σταγόνες του νερού δεν απειλούν την επιβίωσή της και διατηρεί αυτή τη γνώση επί εβδομάδες, χωρίς να διαθέτει εγκέφαλο Είναι δυνατόν ένα φυτό να μαθαίνει και… Read More ›
Οι ιοί στη μάχη για τη θεραπεία του καρκίνου
Τις τελευταίες δεκαετίες έχουν γίνει μεγάλα βήματα στη θεραπεία του καρκίνου και εμπνευσμένοι επιστήμονες, σχεδιάζοντας νέες θεραπείες και ακολουθώντας επαναστατικές προσεγγίσεις, έχουν ήδη καταφέρει να θεραπεύσουν κάποια είδη καρκίνων. Παρ’ όλα αυτά, εκατομμύρια άνθρωποι πεθαίνουν από την απειλητική αυτή ασθένεια…. Read More ›
Oι ταλαντώσεις των πρωτεϊνών
Νέα Υόρκη Μια νέα απεικονιστική τεχνική που χρησιμοποίησαν ερευνητές του Πανεπιστημίου του Μπάφαλο και του Ερευνητικού Ιατρικού Ινστιτούτου Χάουπτμαν-Γούντγουορντ, στις ΗΠΑ, απέδειξε ότι, οι πρωτεΐνες του ανθρώπινου οργανισμού δονούνται όπως και οι χορδές ενός μουσικού οργάνου. Η νέα αυτή πληροφορία ανοίγει τον δρόμο… Read More ›
Βίντεο: αράχνη χρησιμοποιεί τoν ιστό της ως σφεντόνα
Λίμα, Περού Μια μικρή αράχνη του Αμαζονίου κάνει θραύση στο YouTube χάρη σε ένα μοναδικό βίντεο που τη δείχνει να χρησιμοποιεί τον ιστό της σαν σφεντόνα για να γραπώσει περαστικά έντομα. Τα ασυνήθιστα ακροβατικά ανακαλύφθηκαν χάρη στην παρατηρητικότητα του Τρόι… Read More ›
4 επιστημονικά επιτεύγματα του 2013 που ξεχωρίζουν
Στο βάθος του Γαλαξία και ακόμη πιο βαθιά στην καρδιά του DNA έφθασε η επιστήμη τη χρονιά που πέρασε, αναδεικνύοντας το 2013 σε κομβικό έτος για την κατάκτηση του Διαστήματος, για την αντιμετώπιση του καρκίνου και της έλλειψης οργάνων για… Read More ›
Οι 10 σημαντικότερες εξελίξεις του 2013 …
… σύμφωνα με το Science Ουάσινγκτον Η ανοσοθεραπεία κατά του καρκίνου, δηλαδή η στρατολόγηση του ανοσοποιητικού συστήματος για την εξουδετέρωση των όγκων, ανακηρύχθηκε από το Science τo σημαντικότερο επίτευγμα του 2013, «έτος καμπής» στον πόλεμο κατά του καρκίνου. Το κορυφαίο… Read More ›
Εκτύπωσαν με επιτυχία νέα κύτταρα ματιού
Επιστήμονες κατάφεραν να εκτυπώσουν με επιτυχία νέα κύτταρα ματιού, τα οποία ενδεχομένως να μπορούν να χρησιμοποιηθούν στο μέλλον για την θεραπεία της τύφλωσης Βρετανοί ερευνητές για πρώτη φορά εκτύπωσαν με επιτυχία νέα οφθαλμικά κύτταρα. Το επίτευγμα ανοίγει το δρόμο για… Read More ›
Βρέθηκε δεύτερος κώδικας κρυμμένος στο DNA
Διπλή γλώσσα μιλάει το DNA μας Ερευνητές με Έλληνα επικεφαλής υποστηρίζουν ότι μέσα στον γενετικό μας κώδικα υπάρχει κρυμμένος και ένας δεύτερος Έναν δεύτερο κώδικα που κρύβεται μέσα στο ανθρώπινο DNA υποστηρίζουν ότι ανακάλυψαν ερευνητές του Πανεπιστημίου της Ουάσινγκτον στο… Read More ›
Ο αρχαιότερος πρόγονός μας είναι ένα… ζελέ
Μια σημαντική ανακάλυψη, με τη συμμετοχή ενός Έλληνα επιστήμονα της διασποράς, του δρος Ανδρέα Βαξεβάνη, αλλάζει τα δεδομένα, τοποθετώντας στη θέση του αρχαιότερου προγόνου μας ένα…ζελέ, συγκεκριμένα ένα ζελατινώδες πλάσμα της θάλασσας, που ανήκει στα λεγόμενα κτενοφόρα.Οι επιστήμονες έως τώρα… Read More ›
Συνθετικά κύτταρα «μιμούνται την εμφάνιση ζωής στη Γη»
Βοστόνη, Μασαχουσέτη Συνθετικά «κύτταρα» που περιέχουν μόρια RNA ως γενετικό υλικό και μπορούν να αναπαράγονται δημιουργήθηκαν από ερευνητές στις ΗΠΑ σε μια προσπάθεια να προσομοιωθεί η εμφάνιση των πρώτων ζωντανών οργανισμών του πλανήτη. «Βρήκαμε τη λύση σε ένα παλιό πρόβλημα… Read More ›
Τα αρχαιότερα ίχνη ζωής βρέθηκαν στην Αυστραλία
Σίδνεϊ Περίπου ένα δισεκατομμύριο χρόνια μετά το σχηματισμό της Γης, μια πρωτόγονη μικροβιακή γλίτσα κάλυπτε τα βράχια ενός αρχαίου, παράκτιου οικοσυστήματος. Ο μικροβιακός τάπητας άφησε ίχνη στα αρχαιότερα πετρώματα του πλανήτη, ίχνη που είναι πιθανότατα οι αρχαιότερες ενδείξεις ζωής, εκτιμούν… Read More ›
Tersicoccus phoenicis: πολύ σκληρό… βακτήριο για να πεθάνει
Σχεδόν εξωγήινo είδος βακτηρίου κρυβόταν στα καθαρότερα εργαστήρια της NASA Ξηραίνουμε την ατμόσφαιρα, καθαρίζουμε όλες τις επιφάνειες με χημικά και τέλος αποστειρώνουμε το χώρο με υπεριώδη ακτινοβολία. Αυτό που μένει είναι ορισμένα από τα πιο ανθεκτικά μικρόβια του κόσμου, πιθανώς… Read More ›
Γενετιστές αλλάζουν τον γενετικό κώδικα
Γενετιστές στην Ιατρική Σχολή του Χάρβαρντ κατάφεραν να αλλάξουν τη γλώσσα στην οποία είναι γραμμένες οι γενετικές πληροφορίες ενός βακτηρίου, ένα επίτευγμα που θα μπορούσε να αξιοποιηθεί για την παραγωγή εντελώς νέων μορίων στη βιομηχανία βιοτεχνολογίας, ενώ ταυτόχρονα θα μπορούσε… Read More ›
Το βραβείο Νόμπελ Ιατρικής 2013 …
… στην ενδοκυτταρική κυκλοφορία (νεώτερη ενημέρωση) To βραβείο Νόμπελ Ιατρικής ή Φυσιολογίας 2013 απονεμήθηκε στους Αμερικανούς James Rothman (Τζέιμς Ρόθμαν), Randy Schekman (Ράντι Σέκμαν) και στον Γερμανό Thomas Südhof (Τόμας Ζίντχοφ) για την έρευνα που διεξήγαγαν σχετικά με το πώς… Read More ›
Παραγωγή βενζίνης από τροποποιημένα μικρόβια!
Μια πρωτοποριακή τεχνολογία παραγωγής βενζίνης από μεταβολικά τροποποιημένους μικροοργανισμούς παρουσίασαν Νοτιοκορεάτες ερευνητές. Είναι ένα ακόμα βήμα -προς το παρόν σε αρχικό στάδιο- σε μια ευρύτερη επιστημονική προσπάθεια διεθνώς για τη σταδιακή απεξάρτηση από τα ορυκτά καύσιμα, τόσο για οικονομικούς, όσο… Read More ›
Από τη ναζιστική επιστήμη στη σύγχρονη βιοτεχνολογία
Το φάντασμα της ευγονικής Υπάρχουν δύο, άλλοτε συμπληρωματικές και άλλοτε αλληλοαποκλειόμενες εκδοχές της ευγονικής: η «θετική» ευγονική οδηγεί στην ενίσχυση των επιθυμητών κληρονομικών χαρακτηριστικών, ενώ η «αρνητική» ευγονική αποβλέπει στην εξάλειψη κάποιων χαρακτηριστικών ή των φορέων τους. Αυτή η εγγενής… Read More ›
Ιχνη από «αρχαίους» μικρο – οργανισμούς
Έζησαν πριν από 100.000 χρόνια Ίχνη από «αρχαίους» μικροοργανισμούς ανακάλυψαν Βρετανοί στη λίμνη Hodgson στην Ανταρκτική Του Κώστα Δεληγιάννη Ενδείξεις μικροοργανισμών που έζησαν πριν από περίπου 100.000 χρόνια ανακάλυψαν στον πυθμένα της λίμνης Hodgson, στη χερσόνησο της Ανταρκτικής, επιστήμονες από… Read More ›
Βρήκαν εξωγήινους μικρο – οργανισμούς;
Βρετανοί ερευνητές ισχυρίζονται ότι εντόπισαν «εξωγήινη μορφή ζωής» σε ύψος 27 χιλιομέτρων πάνω από την επιφάνεια της Γης !Την απόδειξη ύπαρξης εξωγήινης ζωής στο Διάστημα υποστηρίζουν ότι ανακάλυψαν επιστήμονες του Πανεπιστημίου του Σέφιλντ, οι οποίοι έδωσαν την Παρασκευή τις εικόνες… Read More ›
Stephen Hawking, ο Μοριακός Βιολόγος
O Stephen Hawking είναι γνωστός για την έρευνά του στην κοσμολογία, τις μαύρες τρύπες, την σχετικότητα και την κβαντική φυσική, καθώς επίσης και για την ασθένεια που τον έχει αφήσει σχεδόν εντελώς παράλυτο. Στο βίντεο που ακολουθεί ακούγονται οι απαντήσεις… Read More ›
Ο άνθρωπος μπορεί να περπατήσει στο νερό όπως ο Χριστός
… στην Σελήνη! Η ανακάλυψη αυτή βραβεύθηκε με το Ιg Nobel Φυσικής Ποιοι τιμήθηκαν με Ιg Nobel στη Χημεία, Βιολογία, Αστρονομία, Ιατρική κ.λπ (updated)) Όπως κάθε χρόνο, τα βραβεία Νόμπελ «παρωδία» Ig προηγούνται των κανονικών βραβείων. Πρόκειται για βραβεία που απονέμονται σε… Read More ›
Mια επιστημονική ερμηνεία των εντυπωσιακών επιθανάτιων εμπειριών
Μια νέα επιστημονική εξήγηση για τις εντυπωσιακές επιθανάτιες εμπειρίες που αναφέρουν αρκετοί ασθενείς, οι οποίοι «γύρισαν» στη ζωή από τον παραλίγο θάνατό τους, δίνει μια νέα αμερικανική επιστημονική έρευνα που για πρώτη αφορά εξέτασε συστηματικά τη νευροφυσιολογική κατάσταση του εγκεφάλου… Read More ›
Εγκεφαλικά κύτταρα που παίζουν τον ρόλο GPS
Ανακαλύφθηκαν κύτταρα που βοηθούν τους ανθρώπους να βρίσκουν τον δρόμο τους σε άγνωστα περιβάλλοντα Αμερικανοί επιστήμονες εντόπισαν για πρώτη φορά σε ανθρώπους εξειδικευμένα εγκεφαλικά κύτταρα που παίζουν τον ρόλο GPS, δηλαδή βοηθούν στο να βρίσκει κανείς τον δρόμο του και… Read More ›
Ένα τούβλο είναι ουσιώδες αντικείμενο;
Ο Richard Feynman θέτει φιλοσοφικά ερωτήματα Στο Scientific American δημοσιεύθηκε πριν από λίγες ημέρες ένα ενδιαφέρον άρθρο με τίτλο «Feynman on Biology« της Christina Agapakis. Και δεν θα μπορούσε βέβαια να μην αναφέρεται στις εμπειρίες που περιγράφει o Feynman, από την… Read More ›
H ηλεκτροστατική παγίδα της αράχνης
Μπέρκλεϊ, Καλιφόρνια Η αράχνη η διαδηματοφόρος, ένα είδος που απαντάται και στην Ελλάδα, υφαίνει ιστούς που φορτίζονται με στατικό ηλεκτρισμό και ασκούν μια θανατηφόρο έλξη σε φορτισμένα έντομα όπως οι μέλισσες, αποκαλύπτουν κάμερες υψηλής ταχύτητας. Προηγούμενες μελέτες έχουν δείξει ότι… Read More ›
Οι τελευταίοι οργανισμοί που θα επιζήσουν στη Γη
Τα τελευταία πλάσματα που θα επιζήσουν στη Γη θα είναι αυτά που έζησαν πρώτα, δηλαδή οι μικροοργανισμοί που διαβιούν στο υπέδαφος. Αυτή η εκτίμηση είναι σύμφωνα με μία νέα βρετανική επιστημονική μελέτη, η οποία κάνει εκτιμήσεις για την μοίρα του… Read More ›
Κλωνοποίηση ποντικιού από μία σταγόνα αίμα
Επιστήμονες στην Ιαπωνία ανακοίνωσαν ότι κατάφεραν να κλωνοποιήσουν ένα ποντίκι χρησιμοποιώντας μόνο μια σταγόνα αίματος, την οποία πήραν από την ουρά ενός άλλου ποντικιού-δωρητή. Ο θηλυκός κλώνος είχε μια φυσιολογική ζωή και γέννησε υγιείς απογόνους. Οι ερευνητές του Κέντρου Βιολογίας… Read More ›
Ο λεπτομερέστερος ψηφιακός χάρτης του εγκεφάλου
Η Γη διαθέτει τους ψηφιακούς χάρτες του Google Earth και ο ανθρώπινος εγκέφαλος απέκτησε κάτι ανάλογο χάρη σε έναν νέο ανατομικό «άτλα», ο οποίος ονομάζεται «Μεγάλος Εγκέφαλος» (Big Brain). Πρόκειται για τη λεπτομερέστερη μέχρι σήμερα τρισδιάστατη ψηφιακή χαρτογράφηση του εγκεφάλου…. Read More ›
Η αρχαία σαύρα με το όνομα του Jim Morrison
Απολίθωμα τεράστιας αρχαίας σαύρας πήρε το όνομα του τραγουδιστή των Doors Jim Morrison Ο διάσημος τραγουδιστής και στιχουργός Τζιμ Μόρισον του ροκ συγκροτήματος Doors πέθανε το 1971, αλλά από τότε ο τάφος του στο Παρίσι, στο νεκροταφείο Περ Λασέζ, δεν… Read More ›
Ανάσταση φυτών που είχαν παγώσει πριν 4 αιώνες
Οι επιστήμονες θεωρούν ότι αυτή η αναπάντεχη «ανάσταση» δείχνει πώς τα φυτικά οικοσυστήματα του πλανήτη έχουν καταφέρει να ανακάμψουν μετά από τις εποχές των παγετώνων. Φυτά που είχαν παγώσει πριν από 400 περίπου χρόνια, στη διάρκεια της λεγόμενης «Μικρής Εποχής… Read More ›
Πώς εμφανίστηκε η φωτοσύνθεση;
H ανακάλυψη ενός μονοκύτταρου φύκους που καταπίνει ολόκληρα βακτήρια προσφέρει νέα στήριξη στην κρατούσα θεωρία για το πώς εμφανίστηκε η φωτοσύνθεση πριν από ένα δισεκατομμύριο και πλέον χρόνια. Οι βιολόγοι υποψιάζονται εδώ και καιρό ότι οι πρώτοι οργανισμοί που εξέλιξαν… Read More ›
Βακτήρια ως «ζωντανοί» υπολογιστές
Μηχανικοί του ΜΙΤ μετέτρεψαν βακτηριακά κύτταρα σε «ζωντανούς» υπολογιστές, που είναι σε θέση να υπολογίσουν λογαρίθμους, να κάνουν διαιρέσεις και να εξάγουν τετραγωνικές ρίζες, χρησιμοποιώντας τρία ή και λιγότερα γενετικά τμήματα. Η όλη ιδέα προήλθε από τον τρόπο λειτουργίας των… Read More ›
Σκοπός του σύμπαντος είναι η δημιουργία μαύρων τρυπών;
Μήπως το σύμπαν εξελίσσεται για να δημιουργεί μαύρες τρύπες; Τα μαθηματικά πίσω από τη θεωρία του Δαρβίνου για τη φυσική επιλογή μπορούν να εξηγήσουν πώς το σύμπαν έχει «σχεδιαστεί» για να δημιουργεί μαύρες τρύπες Νέα έρευνα του Πανεπιστημίου της Οξφόρδης:… Read More ›
Βακτήρια παράγουν πετρέλαιο
Ερευνητική ομάδα του Πανεπιστημίου του Έξετερ ανέπτυξε μία μέθοδο κατά την οποία βακτήρια παράγουν πετρέλαιο κατά παραγγελία Βρετανοί επιστήμονες δημιούργησαν γενετικά τροποποιημένα βακτήρια – «διυλιστήρια», που μπορούν να παράγουν βιοκαύσιμα ντίζελ. Αν τα επόμενα χρόνια καταστεί εφικτό αυτή η διαδικασία… Read More ›
Διάβασαν το γονιδίωμα ενός «ζωντανού απολιθώματος»
Η αποκωδικοποίηση του DNA του κοιλάκανθου δείχνει πολλά και για τη δική μας εξέλιξη Τα γενετικά μυστικά ενός «ζωντανού απολιθώματος» τα οποία μαρτυρούν πολλά και για τη δική μας εξέλιξη αποκάλυψε διεθνής ομάδα ερευνητών. Οι επιστήμονες αποκωδικοποίησαν ολόκληρο το γονιδίωμα… Read More ›
Νέα στοιχεία για την πρώτη εμφάνιση ζωής στη Γη
Η έρευνα διήρκεσε τρία χρόνια και βασίστηκε σε ερευνητικές τεχνικές οι οποίες αναπτύχθηκαν σε βάθος 17 ετών Δομικός βιολόγος του Πανεπιστημίου Φλόριντα Στέιτ ανακοίνωσε ανακαλύψεις που μπορούν να οδηγήσουν την επιστημονική κοινότητα ένα βήμα πιο κοντά στο να κατανοήσουν πώς… Read More ›
Βίντεο: η επιστήμη των γάτων
Διαβάστε επίσης: Γατική Φυσική
Hλεκτρικό ρεύμα από βιο-μπαταρίες με βακτήρια
Ένα βήμα πιο κοντά στην παραγωγή «καθαρού» ηλεκτρισμού από βακτήρια μέσω της ανάπτυξης των σχετικών βιο-μπαταριών, ήρθαν βρετανοί και αμερικανοί επιστήμονες. Οι ερευνητές απέδειξαν ότι τα βακτήρια δημιουργούν ηλεκτρικό φορτίο από μόνα τους -το οποίο δεν ήταν σαφές μέχρι σήμερα…. Read More ›
Μαθηματικό μοντέλο εξηγεί την προέλευση της ζωής
Χρησιμοποιεί στοιχεία από τη θεωρία Ginzburg–Landau για την υπεραγωγιμότητα Μία διεθνής ομάδα φυσικών δημιούργησε μαθηματικά μοντέλα βιολογικών καταστάσεων χρησιμοποιώντας ενεργειακά κύματα με την ονομασία σολιτόνια, προκειμένου να ανακαλύψει το πώς οι πρώτες μορφές ζωής έκαναν το άλμα από τον αβιοτικό… Read More ›
Μια ιστορική επιστολή του Francis Crick …
…για την ανακάλυψη του DNA Πρόκειται για την επιστολή που έγραψε ο Francis Crick το 1953 στον δωδεκάχρονο τότε γιο του, λίγες μέρες μετά την ανακάλυψη της διπλής έλικας του DNA. «… o Jim Watson και εγώ κάναμε μάλλον μια… Read More ›
Νέα στοιχεία για τον αστεροειδή που αφάνισε τους δεινόσαυρους
Διεθνής ερευνητική ομάδα από τα πανεπιστήμια της Γλασκώβης, του Άμστερνταμ και του Μπέρκλεϋ πιστεύουν πως προσδιόρισαν τους λόγους και την ακριβέστερη ημερομηνία της εξαφάνισης των δεινοσαύρων, η οποία συμπίπτει με την πρόσκρουση ενός αστεροειδή ή κομήτη στη Γη. Οι ερευνητές… Read More ›
Η δύναμη των χρωμάτων
Ασκούν καταλυτική επιρροή στη διάθεσή μας, συχνά με τρόπο ανεξήγητο. Οι ερευνητές προσπαθούν να δαμάσουν τη δύναμη των χρωμάτων και ορισμένοι αναπτύσσουν θεραπείες που βασίζονται σ’ αυτήν Βενιού Ειρήνη – http://www.tovima.gr Η ζωή μας είναι σαν ένα καλειδοσκόπιο γεμάτο εικόνες… Read More ›
Bακτήριο χρυσοχόος
Ερευνητές κατάφεραν να απομονώσουν μια ουσία που επιτρέπει σε ένα ασυνήθιστο βακτήριο να μετατρέπει τα ιόντα χρυσού σε σωματίδια συμπαγούς χρυσού -η τεχνική που εφαρμόζει το μικρόβιο θα μπορούσε μια μέρα να αξιοποιηθεί για την ανάκτηση χρυσού από τα απορρίμματα… Read More ›
Τι σκέφτεται ένα ψάρι;
Φθορίζουσα πρωτεΐνη μας επιτρέπει να «διαβάσoυμε» τις σκέψεις των ψαριών Τις νοητικές διαδικασίες που λαμβάνουν χώρα στον εγκέφαλο ενός ψαριού, την ώρα που κυνηγά ένα άλλο ψάρι κατάφεραν να βιντεοσκοπήσουν σε πραγματικό χρόνο ιάπωνες επιστήμονες. Στην πραγματικότητα είναι η πρώτη… Read More ›
Η αίσθηση της όσφρησης είναι κβαντική
μια μελέτη με «άρωμα» ελληνικό Είναι η μύτη μας μια «κβαντομηχανή»; Η δική μας δεν ξέρουμε ακόμη, αλλά πάντως της μύγας είναι! Η όσφρηση σε αντίθεση με την όραση και την ακοή, παραμένει ακόμη και σήμερα η λιγότερο μελετημένη αίσθηση…. Read More ›
Τα σκαθάρια προσανατολίζονται με τη βοήθεια του Γαλαξία
Έμπειροι «αστρονόμοι» αποδεικνύονται τα ταπεινά σκαθάρια, καθώς, σύμφωνα με μελέτη σουηδών επιστημόνων, βρίσκουν τον προσανατολισμό τους κοιτάζοντας τα αστέρια. Ο άνθρωπος, τα πουλιά και οι φώκιες ήταν γνωστό ότι χρησιμοποιούσαν τον νυχτερινό ουρανό για τον προσανατολισμό τους. Τώρα όμως, στη… Read More ›
Σαίξπηρ, Μάρτιν Λούθερ Κινγκ και DNA
Tο γενετικό υλικό μας που αποδεικνύεται το τέλειο μέσο ψηφιακής φύλαξης δεδομένων Είναι μια από τις πιο συμβολικές ομιλίες όλων των εποχών η οποία τώρα πια περνά στην… αθανασία με τον πιο ασυνήθιστο τρόπο. Ένα τμήμα της διάσημης ομιλίας «Έχω… Read More ›
Ανακαλύφθηκε DNA με τετραπλή έλικα
… σε ανθρώπινα κύτταρα Εξήντα χρόνια μετά την ιστορική ανακάλυψη της διπλής έλικας του μορίου του DNA από τον βρετανό Φράνσις Κρικ και τον αμερικανό Τζέημς Γουότσον στο Κέμπριτζ, το Φεβρουάριο του 1953, επιστήμονες του ίδιου πανεπιστημίου έκαναν την πρωτοφανή ανακοίνωση ότι για πρώτη… Read More ›
Oι σπόγγοι δεν ήταν τα πρώτα είδη του ζωικού βασιλείου
Οι πρώτοι εκπρόσωποι του ζωικού βασιλείου, από τους οποίους κατάγονται και οι άνθρωποι, πιστεύεται εδώ και δεκαετίες ότι ήταν οι ταπεινοί σπόγγοι. Οι εξελικτικοί βιολόγοι μένουν όμως έκπληκτοι από τα αποτελέσματα των τελευταίων γενετικών αναλύσεων, οι οποίες υποδεικνύουν ότι η… Read More ›
Διπλή έλικα DNA, 50 έτη μετά …
Μισός αιώνας συμπληρώνεται από την απονομή βραβείου Νομπέλ για την ανακάλυψη της δομής του DNA Αλαχιώτης Σταμάτης Ν. – www.tovima.gr Hταν 10.12.1962 και το Νομπέλ Ιατρικής κέρδιζε η συγκλονιστική ανακάλυψη για τη δομή του DNA, που είχε επιτευχθεί το 1953. Πρωταγωνιστής… Read More ›
Spaun: η προσομοίωση του ανθρώπινου εγκεφάλου (βίντεο)
Δείτε ολόκληρη τη σειρά των βίντεο σχετικά με την προσομοίωση Spaun (Semantic Pointer Architecture Unified Network – Ενοποιημένο Δίκτυο Αρχιτεκτονικής Εννοιολογικού Δείκτη) ΕΔΩ: nengo.ca/build-a-brain/spaunvideos/ Ένα μοντέλο λογισμικού με την ονομασία Spaun, που προσομοιώνει τον ανθρώπινο εγκέφαλο, καταφέρνει να παίζει απλά παιχνίδια, να… Read More ›
Ηλεκτρονικό μικροσκόπιο «βλέπει» τη διπλή έλικα του DNA
Πολλά έχουν αλλάξει από τη δεκαετία του 1950, όταν οι επιστήμονες προσδιόρισαν έμμεσα τη δομή του DNA χρησιμοποιώντας ακτίνες Χ και εξυπνάδα. Τώρα, Ιταλοί ερευνητές παρουσιάζουν το πρώτο άμεσο πορτρέτο DNA σε ηλεκτρονικό μικροσκόπιο σάρωσης. Οι νανοπροεξοχές είχαν σχεδιαστεί προσεκτικά… Read More ›
Bρέθηκε μόριο που ίσως ήταν ο πρόγονος του DNA
Ένα μόριο που μπορεί να σχηματίζει πολυμερείς ενώσεις ανιχνεύθηκε για πρώτη φορά στη φύση, ενισχύοντας έτσι την ανεπιβεβαίωτη θεωρία ότι ήταν ο χημικός πρόγονος του DNA. Το μόριο AEG, το οποίο θεωρούνται μέχρι τώρα συνθετική ουσία, χρησιμοποιείται ακόμα και σήμερα… Read More ›
Σχέδιο ψηφιακής προσομοίωσης του εγκεφάλου
Επιμέλεια: Σταύρος ΞΕΝΙΚΟΥΔΑΚΗΣ – rizospastis.gr – Scientific American Η αναγωγική βιολογική εξέταση του εγκεφάλου, δηλαδή η μελέτη μεμονωμένων τμημάτων του, νευρωνικών κυκλωμάτων και κρίσιμων για τη λειτουργία του μορίων, έχει αποδώσει πολλά στην κατανόησή του, αλλά από μόνη της δεν μπορεί… Read More ›
Γιατί το DNA έχει Θυμίνη και όχι Ουρακίλη;
(….) Οι αζωτούχες βάσεις, μπορεί να είναι είτε πουρίνες είτε πυριμιδίνες. Τόσο οι πουρίνες όσο και οι πυριμιδίνες είναι κυκλικές αρωματικές ενώσεις που περιέχουν άτομα C, N, H. Παράγωγα της πουρίνης είναι η Αδενίνη και η Γουανίνη, ενώ παράγωγα πυριμιδίνης… Read More ›
Οι βραβευμένες φωτογραφίες του «μικροκόσμου»
Ενας «Μικρός Κόσμος» σε εικόνες Στη συνέχεια βλέπουμε τις 5 πρώτες φωτογραφίες που ξεχώρισαν στον διαγωνισμό της ιαπωνικής Nikon: nikonsmallworld.com – tovima.gr
«Βακτηριακά καλώδια» εξηγούν μυστηριώδη ηλεκτρικά ρεύματα στο βυθό
Η ανίχνευση ηλεκτρικών ρευμάτων στο βυθό της θάλασσας είχε προκαλέσει αίσθηση πριν από τρία χρόνια, μέχρι σήμερα όμως το φαινόμενο παρέμενε ανεξήγητο. Τώρα, διεθνής ερευνητική ομάδα διαπιστώνει ότι τα ρεύματα οφείλονται σε μακρόστενα βακτήρια που συμπεριφέρονται ως καλώδια για να… Read More ›
O Craig Venter είναι βέβαιος ότι υπάρχει ζωή στον Άρη
Ο Κρεγκ Βέντερ, ο ερευνητής που δημιούργησε το πρώτο συνθετικό γονιδίωμα, θέλει τώρα να στείλει στον Άρη ένα ρομπότ που θα αναζητήσει γενετικό υλικό από εξωγήινα μικρόβια. «Σίγουρα θα υπάρχουν και εκεί μορφές ζωής που βασίζονται στο DNA» είπε ο… Read More ›
Bραβείο Nobel Χημείας 2012
… στους Robert J. Lefkowitz και Brian K. Kobilka για την εργασία τους σχετικά με τους υποδοχείς της G πρωτεΐνης. Η εργασία τους εξηγεί πως τα δισεκατομμύρια των κυττάρων στο σώμα μας αντιλαμβάνονται το περιβάλλον τους. Για μεγάλο χρονικό διάστημα παρέμενε… Read More ›
Μορφή ζωής που τρέφεται με Ουράνιο
Ένας μονοκύτταρος οργανισμός που βρίσκεται σε μια θερμή πηγή κοντά στον Βεζούβιο αντιμετωπίζει την τοξικότητα του ουρανίου άμεσα: «τρώγοντας» αυτό το βαρύ μέταλλο και αντλώντας στη συνέχεια ενέργεια από αυτό. Ένας άλλος μονοκύτταρος οργανισμός που βρίσκεται κοντά σε ένα εγκαταλειμμένο… Read More ›
Ο τέταρτος νόμος της θερμοδυναμικής
Πως οι ζωντανοί οργανισμοί υπακούουν στα αξιώματα της θερμοδυναμικής 1ος νόμος της θερμοδυναμικής: H μεταβολή της εσωτερικής ενέργειας ενός συστήματος είναι ίση με το άθροισμα της θερμότητας που απορροφάται και του εξωτερικού έργου που παράγεται πάνω στο σύστημα: ΔU = Q… Read More ›
Τρυπώντας τρία χιλιόμετρα πάγου στην Ανταρκτική
Έπειτα από 16 χρόνια σχεδιασμού, μια ομάδα Βρετανών επιστημόνων είναι έτοιμη για ένα ταξίδι στην Ανταρκτική, σε μια αποστολή που σκοπεύουν να τρυπήσουν πέντε χιλιόμετρα πάγου, προκειμένου να πάρουν δείγματα από μια λίμνη που δεν έχει δει το φως του… Read More ›
Βηματοδότης σε μέγεθος καρφίτσας
Ένα λιλιπούτειο εμφύτευμα σε ρόλο βηματοδότη που θα μπορούσε να χωρέσει στην κεφαλή μιας καρφίτσας ανέπτυξαν οι ειδικοί του Πανεπιστημίου Στάνφορντ, στις ΗΠΑ. Οι αμερικανοί μηχανικοί κατάφεραν να φτιάξουν μια μικροσκοπική και ενεργειακά αυτόνομη εμφυτεύσιμη συσκευή, η οποία αντλεί την… Read More ›
Tο αγαπημένο ζωάκι του «Φρανκεστάιν»
Η πρώτη στον κόσμο τεχνητή μέδουσα-Φρανκεστάιν που κολυμπάει με καρδιά αρουραίου! http://youtu.be/gfC3eVjmpfo Αν ζούσε ο Φρανκενστάιν, αυτό θα ήταν το αγαπημένο ζωάκι του! Αμερικανοί επιστήμονες δημιούργησαν μία τεχνητή μέδουσα από άψυχη σιλικόνη, που διαθέτει κύτταρα από την καρδιά ενός αρουραίου… Read More ›
Νίκος Λογοθέτης: εξερευνητής της σκέψης
Η χρήση της λειτουργικής μαγνητικής τομογραφίας στην έρευνα του εγκεφάλου θεωρείται δικό του «παιδί» και ο διαπρέπων έλληνας ερευνητής πραγματοποίησε με τη βοήθειά της άλματα στην κατανόηση του πολυτιμότερου οργάνου μας Γράφει ο Βάρβογλης Χάρης – tovima.gr Τι είναι το… Read More ›
Ψηφιακά κυκλώματα με ανθρώπινα κύτταρα
Επιστήμονες από την Ελβετία δημιούργησαν για πρώτη φορά ένα ψηφιακό κύκλωμα που εκτελεί απλές αριθμητικές πράξεις με βάση τα ανθρώπινα κύτταρα. Με εμβρυϊκά κύτταρα ανθρώπινου νεφρού Οι ερευνητές της Ομοσπονδιακής Πολυτεχνικής Σχολής της Ζυρίχης με επικεφαλής τον Μάρτιν Φουσενένγκερ ανέπτυξαν… Read More ›
Αποθήκευση ψηφιακών δεδομένων σε DNA ….
… ζωντανών κυττάρων Αμερικανικό πείραμα μετατρέπει το DNA σε μνήμη RAM Μια πειραματική μέθοδος που επιτρέπει την εγγραφή ψηφιακής πληροφορίας στο γενετικό υλικό βακτηρίων είναι το τελευταίο ορόσημο στο χώρο της συνθετικής πληροφορίας. Ερευνητές του Πανεπιστημίου Στάνφορντ στην Καλιφόρνια χρησιμοποίησαν… Read More ›
Αιωνόβια μικρόβια «ξαναγράφουν» τα όρια μεταξύ ζωής & θανάτου
Οι επιστήμονες ανακάλυψαν μια αξιοσημείωτη κοινότητα πανάρχαιων μικροβίων, που ζουν θαμμένα 30 μέτρα κάτω από το βυθό του Ειρηνικού Ωκεανού, σε πετρώματα ηλικίας 86 εκατ. ετών, δηλαδή πολύ πριν εξαφανιστούν οι δεινόσαυροι, και τα οποία χρησιμοποιούν τόσο μηδαμινό οξυγόνο και… Read More ›
Πριν 2,5 δισ. χρόνια άρχισε να χτυπά το «ρολόι της ζωής»
Το κοινό αρχέγονο βιολογικό ρολόι άρχισε να «χτυπά» πριν από 2,5 δισ. χρόνια. Ένα από τα μεγαλύτερα επιστημονικά μυστήρια είναι πότε και πώς η ζωή δημιούργησε το δικό της ρολόι και άρχισε να κρατά τον χρόνο. Τώρα, για πρώτη φορά… Read More ›
Πιεζοηλεκτρική παραγωγή ενέργειας από ιούς
Έναν καινοτόμο τρόπο παραγωγής ηλεκτρικής ενέργειας από αβλαβείς ιούς, οι οποίοι μετατρέπουν τη μηχανική ενέργεια σε ηλεκτρική, ανέπτυξαν αμερικανοί ερευνητές. Πρόκειται για την πρώτη μικρή γεννήτρια, που παράγει ηλεκτρικό ρεύμα μέσω χειραγώγησης των λεγόμενων πιεζοηλεκτρικών ιδιοτήτων ενός βιολογικού υλικού, όπως… Read More ›
Ο εγκέφαλος των περιστεριών λειτουργεί ως πυξίδα
Oι «νευρώνες GPS» περιστεριών αντιλαμβάνονται μαγνητικά πεδία Τα περιστέρια ταξιδεύουν σε όλο τον κόσμο με τη βοήθεια ενός είδους εσωτερικού συστήματος GPS στον εγκέφαλό τους, το οποίο τους επιτρέπει να αντιλαμβάνονται τα γήινα μαγνητικά πεδία και να προσανατολίζονται ανάλογα. Αυτό… Read More ›
ΧΝΑ (Xeno Nucleic Acid): Το νέο DNA
Τεχνητό γενετικό υλικό μπορεί να μιμηθεί τις ιδιότητες του DNA και του RNA Επιστήμονες βρέθηκαν ένα βήμα πιο κοντά στη σύνθεση νέων μορφών ζωής στο εργαστήριο καθώς έδειξαν ότι τεχνητό γενετικό υλικό που ονομάζεται ΧΝΑ (xeno-nucleic acid) μπορεί να μιμηθεί… Read More ›
Απεικόνιση ζωντανού οργανισμού με μικροσκόπιο σάρωσης ηλεκτρονίων
… για πρώτη φορά To κατάφερε o Yasuhito Ishigaki από το Kanazawa Medical University. Οι μικροοργανισμοί Haemaphysalis flava άντεξαν στον βομβαρδισμό ηλεκτρονίων και τις συνθήκες κενού μέσα σε ένα ηλεκτρονικό μικροσκόπιο σάρωσης (SEM). Για να τον πιστέψουμε πήρε το βίντεο… Read More ›
Αναστήθηκε φυτό ηλικίας 32.000 ετών!
Το Silene stenophylla ήρθε ξανά στη ζωή με χρήση καρπών που βρέθηκαν στους πάγους της Σιβηρίας Θεοδώρα Τσώλη από το tovima.gr Ρώσοι επιστήμονες «ανέστησαν» φυτά ηλικίας 30.000 ετών! Οι ερευνητές του Ινστιτούτου Κυτταρικής Βιοφυσικής μπόρεσαν να καλλιεργήσουν τα φυτά του είδους Silene… Read More ›
Υπερνικώντας την γήινη βαρύτητα
Σταχτοπετρόκλης, ένας ιπτάμενος μετανάστης κατηγορίας φτερού Είναι μικρότερος κι από καχεκτικό σπουργίτι, κι όμως μπορεί να πετά από την Αρκτική μέχρι την Αφρική και πίσω, ένα ταξίδι συνολικής απόστασης 29.000 χιλιομέτρων. Είναι ο σταχτοπετρόκλης, ένα μεταναστευτικό πουλί που εντυπωσίασε τους… Read More ›
Bιολογικό κομπιούτερ αποκρυπτογραφεί εικόνες
… που είναι αποθηκευμένες σε τσιπ από DNA Αμερικανοί και Ισραηλινοί επιστήμονες, δημιούργησαν ένα βιολογικό κομπιούτερ, κατασκευασμένο αποκλειστικά από βιομόρια, που είναι ικανό να αποκρυπτογραφεί εικόνες κωδικοποιημένες σε «τσιπ» από DNA. Αν και το DNA έχει χρησιμοποιηθεί ξανά στο παρελθόν… Read More ›
Posidonia oceanica: Ίσως ο αρχαιότερος ζωντανός οργανισμός στη Γη
Σπόγγοι τα πρώτα ζώα στη Γη και μεσογειακά φύκια οι αρχαιότεροι ακόμα ζωντανοί οργανισμοί του κόσμου. Οργανισμοί που μοιάζουν με σπόγγους και των οποίων τα απολιθώματα ανακαλύφθηκαν στο εθνικό πάρκο Ετόσα της Ναμίμπια στην Αφρική, είναι πιθανότατα τα πρώτα ζώα… Read More ›
Συσκευή που μετατρέπει τις σκέψεις σε λέξεις
«Τηλεπαθητικό» μηχάνημα μετατρέπει σε λέξεις τα εγκεφαλικά κύματα Στο βίντεο που ακολουθεί μπορείτε να ακούσετε την μετατροπή που πέτυχε το μηχάνημα http://youtu.be/rA2H_V_j508 Οι νευροεπιστήμονες έκαναν ένα ακόμα σημαντικό βήμα για το «διάβασμα» του ανθρώπινου νου, με απώτερο στόχο να «ακούσουν»… Read More ›
Το στοιχείο Αρσενικό δεν αποτελεί συστατικό εξωγήινης ζωής
Toν Δεκέμβριο του 2010 η Felisa Wolfe-Simon και οι συνεργάτες της, του Ινστιτούτου Αστροβιολογίας της NASA, δημοσίευσαν μια εργασία τους με τίτλο «Α Bacterium that can grow by using Arsenic instead of Phosphorus» Πριν την ανακοίνωση κυκλοφορούσαν έντονες φήμες για… Read More ›
Οι πρώτες 3D εικόνες μεμονωμένων μορίων
… από ηλεκτρονικό μικροσκόπιο Ουάσινγκτον Ένα συμβατικό ηλεκτρονικό μικροσκόπιο, το οποίο τροποποιήθηκε και βελτιώθηκε στο διάσημο Εθνικό Εργαστήριο Lawrence Berkeley στις ΗΠΑ, έδωσε τις πρώτες τρισδιάστατες εικόνες ενός μορίου πρωτεΐνης οι οποίες είναι αρκετά ευκρινείς ώστε να αποκαλύψουν τη δομή… Read More ›
Μια χαμογελαστή φάτσα μέσα σε κύτταρο
To χαμόγελο μιας πρωτεΐνης H πρωτεΐνη β-κατενίνη αρχικά αναγνωρίστηκε ως μια πρωτεΐνη με κύρια λειτουργία τη σύνδεση μεμβρανικών υποδοχέων με τον κυτταρικό σκελετό. Αυστραλοί ερευνητές του Ινστιτούτου Westmead Millennium για την Έρευνα στην Ιατρική που ερευνούσαν το πώς η πρωτεΐνη… Read More ›
Ηλεκτρομαγνητικά πεδία εναντίον καρκίνου
Η νέα τεχνική πέτυχε να συρρικνώσει τους όγκους σε ασθενείς με καρκίνο στο ήπαρ Eνθαρρυντικά είναι τα πρώτα μηνύματα από τις κλινικές δοκιμές μιας νέας μορφής αντικαρκινικής θεραπείας με τη χρήση χαμηλής έντασης ηλεκτρομαγνητικών πεδίων, σύμφωνα με στοιχεία που δημοσιεύονται… Read More ›
Γιατί τα ζώα προβλέπουν τους σεισμούς;
Πρωτοποριακή έρευνα Βρετανών και Αμερικανών επιστημόνων δίνει απάντηση στο ερώτημα Τα ζώα μπορεί να αντιλαμβάνονται τις χημικές αλλαγές που συμβαίνουν στα επιφανειακά ύδατα λίγο πριν από ένα σεισμό, γεγονός που εξηγεί τη συχνά ανήσυχη συμπεριφορά και την «μαντική» ικανότητά τους,… Read More ›
Η ορχιδέα που ανθίζει μόνο τη νύχτα
Για πρώτη φορά οι βοτανολόγοι ανακάλυψαν μια ορχιδέα που ανθίζει μόνο τη νύχτα. Οι επιστήμονες, που δεν είχαν δει ποτέ κάτι ανάλογο μέχρι τώρα, θεωρούν μυστήρια αυτή τη συμπεριφορά του φυτού. Η ανακάλυψη, που παρουσιάστηκε στο περιοδικό Botanical Journal, σύμφωνα… Read More ›
ΒΙΟΗΛΕΚΤΡΟΝΙΚΗ: Το χάι τεκ τατουάζ που θεραπεύει
ΕΙΝΑΙ ΛΕΠΤΟ ΣΑΝ ΤΡΙΧΑ, ΚΑΝΕΙ ΟΜΩΣ ΤΗ ΔΟΥΛΕΙΑ ΟΓΚΩΔΩΝ ΗΛΕΚΤΡΟΔΙΩΝ ΜΕ ΤΗΝ ΙΔΙΑ ΑΚΡΙΒΕΙΑ Του ED YONG Το «ηλεκτρονικό δέρμα», το οποίο εφηύρε αμερικανική επιστημονική ομάδα, καταγράφει καρδιακούς παλμούς, εγκεφαλική δραστηριότητα και μυϊκές συσπάσεις, με την ακρίβεια που έχουν τα… Read More ›
Διερευνώντας πειραματικά την προέλευση της ζωής
Η ΘΕΩΡΙΑ ΤΗΣ ΠΑΝΣΠΕΡΜΙΑΣ ΣΕ ΕΡΓΑΣΤΗΡΙΟ ΤΟΥ ΕΘΝΙΚΟΥ ΙΔΡΥΜΑΤΟΣ ΕΡΕΥΝΩΝ Η θεωρία της πανσπερμίας, ότι δηλαδή η ζωή στη Γη προέρχεται από μικροοργανισμούς που έφτασαν από το Διάστημα και εξελίχθηκαν, αποδείχτηκε πρόσφατα πειραματικά στο εργαστήριο Νανοφωτονικής του Ινστιτούτου Θεωρητικής και… Read More ›
Βραβείο Nobel Ιατρικής 2011
Το Νομπέλ Ιατρικής δόθηκε στον Αμερικανό Bruce Beutler, τον Jules Hoffmann από το Λουξεμβούργο και τον Ralph Steinman από τον Καναδά. Δυστυχώς ο Ralph Steinman πέθανε την προηγούμενη Παρασκευή μετά από τετράχρονη μάχη με τον καρκίνο στο πάγκρεας. Οι τρεις… Read More ›
Αποστολή κωδικοποιημένων μηνυμάτων με βακτήρια
Κώδικας: κολοβακτηρίδιο Ε. Coli Πρόκειται στην ουσία για νέα βιολογικά barcode, τα οποία αρχικά θα ενσωματωθούν σε ζωντανούς οργανισμούς, σπόρους και καλλιέργειες, ώστε να πιστοποιούν την γνησιότητα τους. Καθόλου τυχαία όμως οι ερευνητές, χρηματοδοτήθηκαν από τη διάσημη υπηρεσία DARPA του… Read More ›
Γιατί τα αμινοξέα των ζωντανών οργανισμών στη Γη είναι αριστερόστροφα;
«…Με την εξέλιξη των μικροσκοπίων στα τέλη του 19ου αιώνα, οι επιστήμονες ξαφνικά απέκτησαν πρόσβαση στον μικρόκοσμο, φέρνοντας στο φως έναν νέο στίβο δράσης της συμμετρίας στον φυσικό κόσμο. Οι δομικοί λίθοι των κρυστάλλων και των πολύτιμων λίθων, των ιστών… Read More ›
Δυσεπίλητο παζλ της Ιατρικής λύθηκε με βιντεοπαιχνίδι
Χρήστες του Διαδικτύου που δέχτηκαν να παίξουν ένα ερευνητικό βιντεοχνίδι κατάφεραν να λύσουν ένα πρόβλημα που ταλαιπωρούσε τους βιολόγους εδώ και μια δεκαετία. Συμμετέχοντας στο διαδικτυκό παιχνίδι Foldit, οι παίκτες προσδιόρισαν την τρισδιάστατη δομή μιας πρωτάσης, ενός ενζύμου που χρησιμοποιούν… Read More ›
Βακτήρια που απομακρύνουν πυρηνικά απόβλητα
Ασυνήθιστες δομές σαν μικροσκοπικά ηλεκτρικά καλώδια επιτρέπουν σε μια ομάδα βακτηρίων να απομακρύνουν το ουράνιο και άλλα τοξικά μέταλλα από τον υδροφόρο ορίζοντα, ανακάλυψαν Αμερικανοί ερευνητές. Η ικανότητα των βακτηρίων Geobacter να οξειδώνουν μέταλλα, ή ακόμα οργανικές τοξικές ουσίες, είχε… Read More ›
Πώς γεννήθηκε η ζωή;
Η επιστήμη βρίσκεται όλο και πιο κοντά στη στιγμή που η ζωή «αναπήδησε» στη Γη Τέσσερα δισεκατομμύρια χρόνια πριν, η επιφάνεια ενός νεοσχηματισμένου πλανήτη που κινείται γύρω από ένα μεσαίου μεγέθους άστρο αρχίζει να ψύχεται. Το μέρος είναι βίαιο, βομβαρδίζεται… Read More ›
Δομικά στοιχεία της ζωής σε μετεωρίτες
Νουκλεοτίδια που εντοπίσθηκαν σε 12 μετεωρίτες ενισχύουν τη θεωρία ότι η ζωή ήρθε στη Γη από το Διάστημα Νέα χημική ανάλυση σε 12 μετεωρίτες δείχνει να ενισχύει τη θεωρία ότι οι δομικοί λίθοι της ζωής έπεσαν στη Γη από τον… Read More ›
Βρέθηκαν απολιθώματα μικροοργανισμών 3,4 δισ. ετών
…που βασίζονταν στο θείο. Νέοι ορίζοντες για την Αστροβιολογία Ανάμεσα στους κόκκους άμμου της αρχαιότερης ακτογραμμής που διατηρείται στην επιφάνεια της Γης, παλαιοβιολόγοι ανακάλυψαν σχηματισμούς που φαίνεται ότι είναι τα αρχαιότερα απολιθώματα που έχουν βρεθεί ως σήμερα: μονοκύτταροι οργανισμοί 3,4… Read More ›
Βίντεο: Δομικές μονάδες του DNA μπορεί να σχηματίστηκαν στο διάστημα
Ερευνητές της NASA έχουν ενδείξεις ότι ορισμένες δομικές μονάδες του μορίου DNA που βρέθηκαν σε μετεωρίτες, δημιουργήθηκαν στο διάστημα. Το μόριο του DNA μεταφέρει τις γενετικές πληροφορίες για τη ζωή. Οι ερευνητές υποστηρίζουν τη θεωρία, σύμφωνα με την οποία «έτοιμα»… Read More ›
Άλματα στην τεχνητή σκέψη
Το όραμα δημιουργίας τεχνητού εγκέφαλου ή βιονικού υπολογιστή βρίσκεται ένα βήμα πιο κοντά στην υλοποίησή του Ο ισχυρότερος υπολογιστής του κόσμου, με 1 δισεκατομμύριο νευρώνες και τις συνάψεις τους, καίει μόλις 20 Watt και βρίσκεται στο κεφάλι μας. Είναι πλέον… Read More ›
Ο έρωτας είναι θέμα Χημείας
Για να αισθανθούμε την ερωτική έλξη, να προσκολληθούμε στο έτερον ήμισυ, αλλά ακόμη και για να το… απατήσουμε, απαιτείται ένας συνδυασμός έκκρισης ορμονών και ενεργοποίησης νευροδιαβιβαστών «Καλοκαίρι, με τη φέτα το καρπούζι στο ένα χέρι…» τραγούδησε προ ετών ο Διονύσης,… Read More ›
Επιστημονική έρευνα για τη δημιουργία του γευστικότερου κοκτέιλ
Τα κοκτέιλ της χημείας Τα μοριακά κοκτέιλ είναι ένα από τα τελευταία επιτεύγματα στο χώρο της μοριακής αναμειξιολογίας (Molecular mixology) η οποία ασχολείται με τη δημιουργία νέων γεύσεων και υλικών με βάση τη μοριακή βιολογία – κλάδος της βιολογίας που… Read More ›
Τα χρονικά της κλωνοποίησης
Η χθεσινή ημέρα – 5η Ιουλίου – ήταν η 15η επέτειος της γέννησης του κλωνοποιημένου προβάτου «Ντόλι». Δεκαπέντε χρόνια πριν, στις 15 Ιουλίου 1996, γεννήθηκε η διάσημη προβατίνα «Ντόλι» -αποτέλεσμα επιτυχημένης διαδικασίας κλωνοποίησης. Η Ντόλι κλωνοποιήθηκε μέσω της διαδικασίας μεταφοράς… Read More ›
Ανθρώπινα κύτταρα μετατρέπονται σε συσκευές λέιζερ
Το ζωντανό λέιζερ στο μικροσκόπιο. Τα ακανόνιστα φωτεινά σχήματα εξαρτώνται από την εσωτερική δομή του κυττάρου Χρησιμοποιώντας ένα ζευγάρι καθρέπτες και την πρωτεΐνη που κάνει κάποιες μέδουσες να φθορίζουν με πράσινο φως, ερευνητές του Χάρβαρντ μετέτρεψαν ανθρώπινα κύτταρα στα πρώτα… Read More ›
Το σκουλήκι "αστροναύτης"
Συνταξιδιώτης με τις αράχνες και το καλαμάρι «αστροναύτες» στο τελευταίο ταξίδι του διαστημικού λεωφορείου Εndeavour ήταν και το σκουλήκι Caenorhabditis elegans. Το «διαστημικό» σκουλήκι θα αποτελέσει οδηγό για τη θωράκιση του ανθρώπινου οργανισµού στο ∆ιάστηµα Πειράµατα µε σκουλήκια που έγιναν στον ∆ιεθνή ∆ιαστηµικό Σταθµό… Read More ›
Μεφίστο: Το σκουλήκι που ζει σε βάθος 1,3 χιλιομέτρων κάτω από την επιφάνεια της Γης
Ερευνητές από τις ΗΠΑ ανακάλυψαν ένα σκουλήκι το οποίο ζει 1,3 χιλιόμετρα κάτω από την επιφάνεια της Γης, το μεγαλύτερο βάθος στο οποίο έχει εντοπιστεί μέχρι σήμερα κάποιος πολυκύτταρος οργανισμός. Halicephalobus Mephisto, γνωστό και ως «Mephisto» Το ονόμασαν Halicephalobus mephisto… Read More ›
Ο παράξενος και υπέροχος κόσμος του βιοφωτισμού
Στον βαθύ και σκοτεινό ωκεανό πολλά πλάσματα δημιουργούν το δικό τους φως για να κυνηγήσουν, να ζευγαρώσουν ή για να αμυνθούν. Αυτό το φως που δημιουργεί η «ζωή» ονομάζεται βιοφωτισμός. Στο βίντεο που ακολουθεί η Edith Widder παρουσιάζει το βάθος… Read More ›
Τι είναι και πώς μεταδίδεται η εντεροαιμορραγική Escherichia coli
Επιδημία από μολυσμένα λαχανικά Το παθογόνο στέλεχος του βακτηρίου Escherichia coli, που ευθύνεται για την επιδημία αιμορραγικής γαστρεντερίτιδας στη Γερμανία, ζει κανονικά στο πεπτικό σύστημα των βοοειδών και άλλων μηρυκαστικών ζώων, χωρίς να τους προκαλεί συμπτώματα….
Τριγμοί στα θεμέλια του «κεντρικού δόγματος» της βιολογίας
To κεντρικό δόγμα προβλέπει ότι η γενετική πληροφορία μεταγράφεται με ακρίβεια από το DNA στο RNA και στη συνέχεια μεταφράζεται σε πρωτεΐνες Σε πολλές περιπτώσεις, τα κύτταρα παραβιάζουν τις κατασκευαστικές οδηγίες που δίνει τo DNA για την παραγωγή πρωτεϊνών, υποδεικνύει… Read More ›
Με ένα τεστ αίματος θα υπολογίζεται ο χρόνος ζωής μας
Ένα τεστ αίματος που θα αποκαλύπτει πόσο γρήγορα γερνάει κανείς – και έτσι θα υπολογίζει σε αδρές γραμμές πόσο θα ζήσει – προγραμματίζεται να διατεθεί αργότερα εφέτος στην βρετανική αγορά. Οι επικριτές του τεστ, που θα κοστίζει 700 δολάρια (495… Read More ›
Σχέδιο «κατάκτησης του εγκεφάλου»
Ο εγκέφαλος είναι το τελευταίο ιατρικό σύνορο που μένει να εξερευνηθεί. Η εξερεύνηση του θα αποτελέσει μια νέα «διαστημική αποστολή αλλά στο εσωτερικό διάστημα» Ο γιος του πρώην γερουσιαστή της Μασαχουσέτης, Έντουαρντ Κένεντι και ανιψιός του προέδρου Τζον Φ. Κένεντι,… Read More ›
Η έλικα που ορίζει τη ζωή μας
Στις 15 Απριλίου γιορτάσαμε την ημέρα DNA, επέτειο της ανακάλυψης της διπλής έλικας που σηματοδοτεί το ποιοί είμαστε και ανοίγει νέους δρόμους για την αντιμετώπιση των προβλημάτων μας. Σ. Ν. ΑΛΑΧΙΩΤΗΣ(*) Η ιστορία της επιστήμης γράφεται από τις σοβαρές ανακαλύψεις… Read More ›
Ένα δηλητήριο στη βάση της ζωής;
Η άκρως τοξική φορμαλδεΰδη ίσως «γέννησε» τα δομικά υλικά της ζωής Λονδίνο Η φορμαλδεϋδη, η οποία είναι εξαιρετικά τοξική για τον άνθρωπο,μπορεί να βοήθησε στην δημιουργία της ζωής στη Γη. Αυτό προέκυψε από μια νέα έρευνα σχετικά με τις συνθήκες… Read More ›
Και η αμοιβάδα κάνει σεξ !
IΩΑΝΝΑ ΣΟΥΦΛΕΡΗ Όταν οι βιολόγοι αναφέρονταν στο «σεξ της αμοιβάδας» το εννοούσαν ως ανέκδοτο, αφού πίστευαν πως κάτι τέτοιο δεν υπάρχει. Μια νέα έρευνα έρχεται να αποκαλύψει ότι και αυτός ο πρωτόγονος οργανισμός επιβιώνει δισεκατομμύρια χρόνια χάρη στη γνωστή συνταγή…… Read More ›
Ο κόσµος των αόρατων ζωυφίων
Ενοχλητικά έντοµα αποκαλύπτει ο φακός µε τη βοήθεια ηλεκτρονικού µικροσκοπίου. Ορισµένα είναι αόρατα µε γυµνό µάτι. Ευτυχώς, γιατί κάποια (όπως οι ψύλλοι) κρύβονται στο µαξιλάρι µας. Κάτω από τον φακό ενός ηλεκτρονικού µικροσκοπίου σάρωσης προβάλλει ένας κόσµος… εφιαλτικός. Η διεισδυτική… Read More ›
Bίντεο: Μια σύντομη εισαγωγή στη Γενετική
Στο βίντεο περιγράφεται η ιστορία της γενετικής, από τον Γκρέγκορ Μέντελ, έως το DNA και τον γενετικό κώδικα. Μετά από μια εισαγωγή στις βασικές ιδέες της γενετικής, παρουσιάζονται οι τεχνικές που χρησιμοποιούνται για τη μελέτη της γενετικής και οι τομείς… Read More ›
Θέμα χημικής ουσίας ο…χορός
Θέλετε να γίνετε Φρεντ Αστέρ; Ο χορός δεν είναι μόνο θέμα εσωτερικού ρυθμού, αλλά και μίας χημικής ουσίας που επιδρά στον εγκέφαλο. Μερικοί άνθρωποι μαθαίνουν πανεύκολα τις νέες κινήσεις ενός χορού και άλλοι είναι ανεπίδεκτοι μαθήσεως. Ορισμένοι χορεύουν με την… Read More ›
Γενετικά τροποποιημένο μικρόβιο «παράγει καύσιμα με φωτοσύνθεση»
Κέμπριτζ Αμερικανική εταιρεία βιοτεχνολογίας ανέπτυξε ένα γενετικά τροποποιημένο κυανοβακτήριο, για το οποίο ισχυρίζεται ότι μπορεί να παράγει φθηνά καύσιμα από σκέτο νερό, διοξείδιο του άνθρακα και ηλιακό φως. Μέχρι όμως να αποδειχθούν οι υποσχέσεις της, πολλοί παραμένουν δύσπιστοι. Η Joule… Read More ›
Το «αρσενοβόρο» βακτήριο: επιστημονική αστοχία ή υπερβάλλων ζήλος;
EΠΙΣΤΗΜΟΝΙΚΟ ΣΧΟΛΙΟ ΤΟΥ ΚΑΘΗΓΗΤΗ KΩΣΤΑ ΔΡΑΪΝΑ Πρόσφατα δημοσιεύτηκε ένα άρθρο στο υψηλού κύρους περιοδικό «Science» με τίτλο «Ενα βακτήριο που μπορεί να αναπτύσσεται με τη χρήση αρσενικού αντί φωσφόρου». Το βακτήριο αυτό απομονώθηκε από τη λίμνη Μono της Καλιφόρνιας, ένα… Read More ›